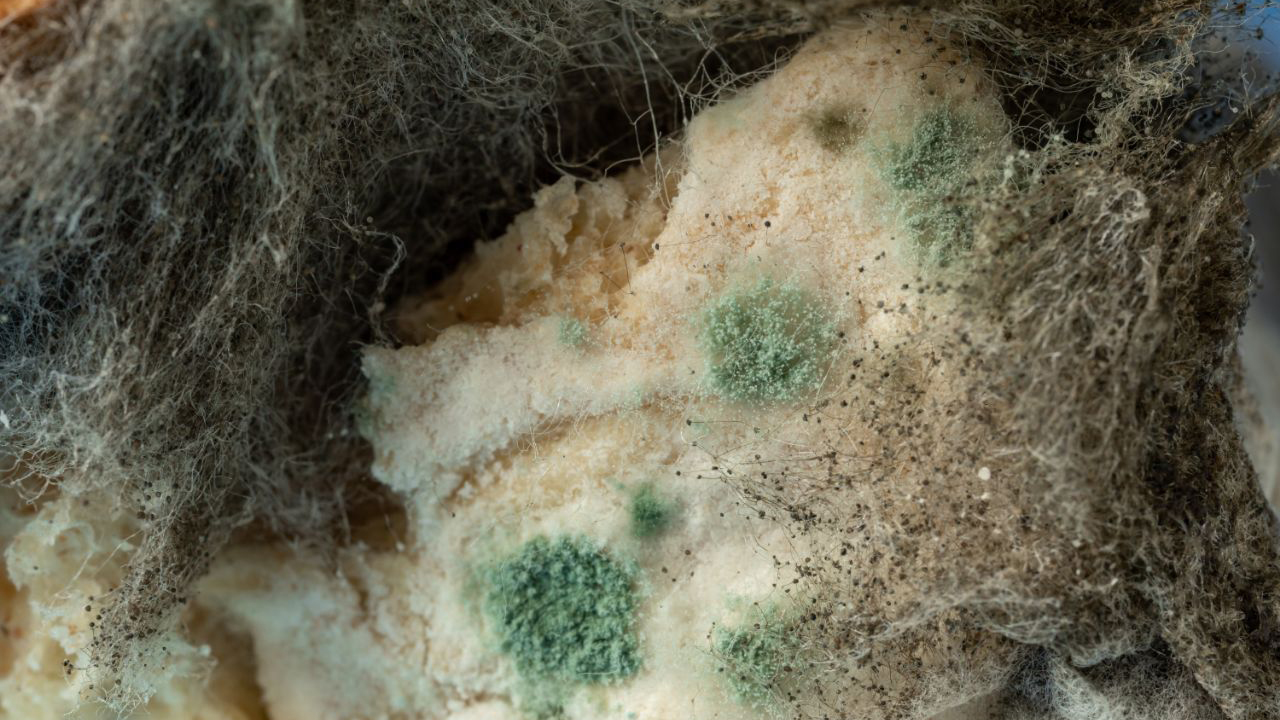
Types of Toxic Mold: Identifying Various Fungus & Understanding Their Health Risks

Learn How to Get Rid of Black Mold Safely & Effectively
What do you do when you see black mold in your home? There’ll be a lot of questions, such as, “How did it get there?” and “Is it dangerous.” But most importantly, you’ll want to know how to get rid of black mold quickly and safely.